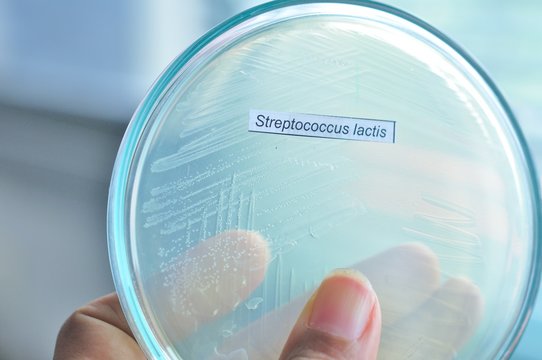
colony of bacteria in microbiology laboratory

- Home >
- Stock Photos >
- Colorful Heart and Geometric Shapes with Digital Sphere
Colorful Heart and Geometric Shapes with Digital Sphere Image

Multicolor heart forms connection with advancing digital sphere and vibrant shapes on black background. Perfect for topics in digital art, connection technology, love in the digital age, or vibrant designs in advertorials or innovative tech initiatives.
2
downloads
downloads
Tags:
More
Credit Photo
If you would like to credit the Photo, here are some ways you can do so
Text Link
photo Link
<span class="text-link">
<span>
<a target="_blank" href=https://pikwizard.com/photo/colorful-heart-and-geometric-shapes-with-digital-sphere/65a54c65bb4dcfbd09b218fc7b4a3929/>PikWizard</a>
</span>
</span>
<span class="image-link">
<span
style="margin: 0 0 20px 0; display: inline-block; vertical-align: middle; width: 100%;"
>
<a
target="_blank"
href="https://pikwizard.com/photo/colorful-heart-and-geometric-shapes-with-digital-sphere/65a54c65bb4dcfbd09b218fc7b4a3929/"
style="text-decoration: none; font-size: 10px; margin: 0;"
>
<img src="https://pikwizard.com/pw/medium/65a54c65bb4dcfbd09b218fc7b4a3929.jpg" style="margin: 0; width: 100%;" alt="" />
<p style="font-size: 12px; margin: 0;">PikWizard</p>
</a>
</span>
</span>
Free (free of charge)
Free for personal and commercial use.
Author: Creative Art